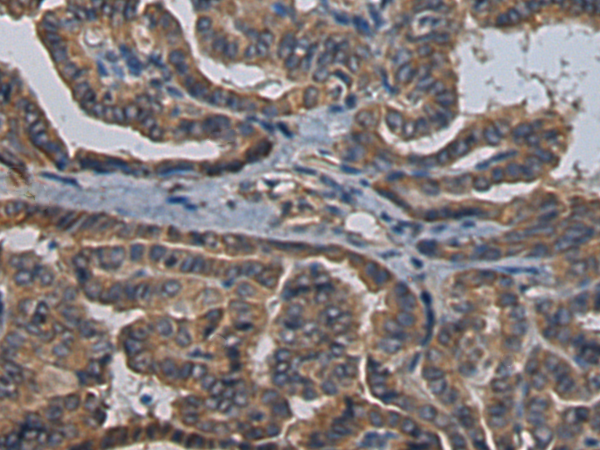

别名:CALP; KCHIP4应用:WB,IHC
反应种属:Human, Mouse, Rat
规格:50μl/100μl
| Description |
|---|
| This gene encodes a member of the family of voltage-gated potassium (Kv) channel-interacting proteins (KCNIPs), which belong to the recoverin branch of the EF-hand superfamily. Members of the KCNIP family are small calcium binding proteins. They all have EF-hand-like domains, and differ from each other in the N-terminus. They are integral subunit components of native Kv4 channel complexes. They may regulate A-type currents, and hence neuronal excitability, in response to changes in intracellular calcium. This protein member also interacts with presenilin. Multiple alternatively spliced transcript variants encoding distinct isoforms have been identified for this gene. |
| Specification | |
|---|---|
| Aliases | CALP; KCHIP4 |
| Swissprot | Q6PIL6 |
| WB Predicted band size | 29 kDa |
| Host/Isotype | Rabbit IgG |
| Storage | Store at 4°C short term. Aliquot and store at -20°C long term. Avoid freeze/thaw cycles. |
| Species Reactivity | Human, Mouse, Rat |
| Immunogen | Fusion protein of human KCNIP4 |
| Formulation | pH7.4 PBS, 0.05% NaN3, 40% Glycerol |
| Application | |
|---|---|
| WB | 1/500-1/2000 |
| IHC | 1/100-1/200 |
| ELISA | 1/5000-1/10000 |
![]() |
Gel: 12%SDS-PAGE, Lysate: 40 μg, Lane 1-2: Human cerebrum tissue, Rat brain tissue lysates, Primary antibody: P03066(KCNIP4 Antibody) at dilution 1/900, Secondary antibody: Goat anti rabbit IgG at 1/5000 dilution, Exposure time: 30 seconds |
![]() |
The image is immunohistochemistry of paraffin-embedded Human esophagus cancer tissue using P03066(KCNIP4 Antibody) at dilution 1/120. (Original magnification: ×200) |
![]() |
The image is immunohistochemistry of paraffin-embedded Human thyroid cancer tissue using P03066(KCNIP4 Antibody) at dilution 1/120. (Original magnification: ×200) |
本公司的所有产品仅用于科学研究或者工业应用等非医疗目的,不可用于人类或动物的临床诊断或治疗,非药用,非食用。
暂无评论
本公司的所有产品仅用于科学研究或者工业应用等非医疗目的,不可用于人类或动物的临床诊断或治疗,非药用,非食用。
中文

发表回复